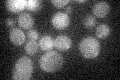
YLR176C
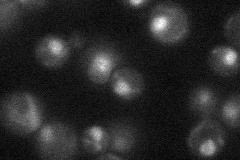
YLR176C

View description
Major transcriptional repressor of DNA-damage-regulated genes, recruits repressors Tup1p and Cyc8p to their promoters; involved in DNA damage and replication checkpoint pathway; similar to a family of mammalian DNA binding RFX1-4 proteins
Localization:
Intensity:
Fold change:
Significance:
-
C’ GFP library in SD
below threshold17.1 -
N' NOP1pr-GFP in SD
nucleus24.124 -
N' TEF2pr-mCherry in SD

below threshold5.59116 -
N' NATIVEpr-GFP in SD

below threshold19.7828 -
N' TEF2pr-VC and Cyto-VN in SD

#N/A0 -
C’ GFP library in SD+DTT

cytosol15.690.91No -
C’ GFP library in SD+H2O2

cytosol16.580.96No -
C’ GFP library in Starvation Media

cytosol14.60.85No -
C’ GFP library on the background of Pup2-DaMP

below threshold -
C’ GFP library on the background of CCT mutant

below threshold17.6321.03039No
